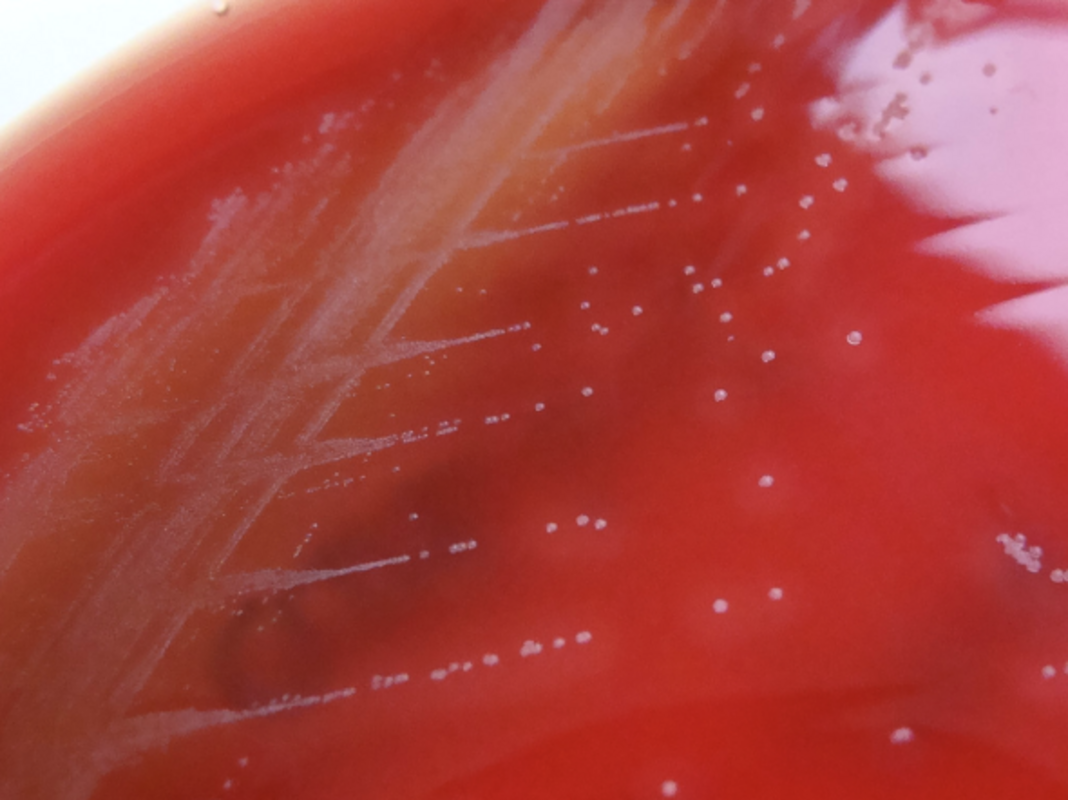

Развитие таких технологий, как масс-спектрометрия, ПЦР и полногеномное секвенирование, дало клиническим микробиологам возможность более эффективно и точно идентифицировать организмы.
Хотя эти технологические разработки имеют решающее значение для обеспечения превосходного лечения пациентов, они быстро вытесняют традиционные микробиологические методы, которые по-прежнему могут быть полезными, простыми в исполнении и экономически эффективными. Хотя новые методики тестирования могут дать ответ быстрее, клиницист и клинический микробиолог также должны хорошо понимать, какого патогена следует ожидать, исходя из истории болезни. Почему? История болезни дает представление о том, какой патоген может вызвать инфекцию, и позволяет микробиологу оптимизировать методы культивирования и идентификации, а также интерпретировать результаты более современных методов исследования, таких как MALDI-TOF MS и ПЦР. Фактически, сбор анамнеза настолько важен, что микробиолог может определить причину инфекции на основании истории болезни и всего нескольких простых микробиологических тестов.
Задача врача - провести дифференциальную диагностику, а задача микробиолога - определить предполагаемый возбудитель и его профиль чувствительности к антибиотикам, используя методы диагностики и имеющиеся знания о возбудителе и его соответствующих характеристиках. Клинические микробиологи предоставляют до 70% данных лабораторной медицины, необходимых врачу/клиницисту для постановки точного диагноза и составления плана лечения.
Пациенты с историей контакта с пресной водой
Пример истории болезни: подросток поступает с некротической раной на ноге после аварии на гидроцикле на озере.
Когда пациент поступает с раневой инфекцией после любого вида воздействия пресной воды, микробиологу на ум должен прийти один патоген: Aeromonas. Представители этого рода были выделены практически из всех типов источников воды, включая пресную, солоноватую, питьевую и загрязненную воду. Если пациент получил травму конечности, подвергаясь воздействию одного из этих источников воды, вероятным виновником является Aeromonas. Кроме того, любое медицинское применение пиявок в анамнезе должно быть большим красным флажком Aeromonas для микробиолога! Пиявки всегда колонизированы бактериями Aeromonas, поскольку они помогают им переваривать их кровь, поэтому применение пиявок также сопряжено с риском заражения Aeromonas. Учитывая эту предварительную информацию, микробиолог должен искать в культуре следующие характеристики:

Окрашивание по Граму Aeromonas, демонстрирующее короткие, пухлые, грамотрицательные палочки.
Рост на плотных средах: влажные и иногда расползающиеся колонии на кровяном агаре. >90% изолятов являются бета-гемолитическими. Не ферментирует лактозу на агаре МакКонки.

Колонии Aeromonas hydrophila и крупный план колоний Aeromonas hydrophila. (Слева) Колонии Aeromonas hydrophila, демонстрирующие большие расползающиеся колонии и бета-гемолиз. (Справа) Крупный план колоний Aeromonas hydrophila на кровяном агаре. Обратите внимание, что колонии выглядят влажными.
Простые тесты: виды Aeromonas являются оксидазоположительными.
Как узнать, что это не Pseudomonas aeruginosa: когда изоляты P. aeruginosa помещают под ультрафиолетовую лампу, они флуоресцируют. Aeromonas этого не делает. Кроме того, Aeromonas ферментирует глюкозу, а P. aeruginosa - нет.
Как эта предположительная идентификация может помочь клиницисту: можно сделать много общих предположений о характере чувствительности Aeromonas, и профиль чувствительности этой группы, похоже, не сильно изменился по сравнению с тем, что было опубликовано в 1980-х и 1990-х годах. Клиницисты могут использовать эти существующие опубликованные данные для руководства лечением и отказа от ненужного лечения противопсевдомонадными препаратами.
Другие пресноводные и солоноватоводные организмы, которые следует рассмотреть: Edwardsiella tarda, Erysipelothrix spp., Vibrio vulnificus и Mycobacterium marinum.
Пациенты с историей воздействия соленой воды
Пример истории болезни: Женщина-диабетик обратилась с быстро прогрессирующей инфекцией стоп и ног. Она отрицает какие-либо необычные воздействия, но сообщает, что плавала в океане и ходила по пляжу босиком. Культуры ее крови положительны.
Хотя заражение Vibrio vulnificus относительно редко встречается, этот организм является естественным обитателем прибрежных вод и может вызывать опасные для жизни инфекции. Кроме того, Vibrio является солелюбивым организмом, и его следует подозревать, если у пациента есть опыт попадания соленой воды на рану. Употребление сырых устриц также связано с заражением Vibrio, особенно V. vulnificus.

Окрашивание по Граму Vibrio показывает изогнутые, грамотрицательные палочки.
Как история болезни помогает микробиологу: если микробиолог подозревает наличие Vibrio, учитывая историю контакта с соленой водой, он может использовать селективную среду, которая стимулирует рост Vibrio, подавляя при этом рост других патогенов. Такие селективные среды могут содержать соли, желчь или различные антибиотики для селекции видов Vibrio. Использование соответствующих селективных и дифференциальных сред в первый же день приводит к более успешному выделению и идентификации организмов.
Простой тест: Виды Vibrio являются оксидазоположительными.
Как узнать, что это не Pseudomonas или Aeromonas: Окраска по Граму видов Vibrio обычно выявляет изогнутые палочки. Если окраска по Граму показывает изогнутую грамотрицательную палочку, микробиолог может быть уверен, что это не Aeromonas, Plesiomonas или Pseudomonas, которые все являются прямыми грамотрицательными палочками. Кроме того, использование селективных сред, таких как тиосульфатно-цитратная среда с желчными солями сахарозы (TCBS), позволяет выделить Vibrio, поскольку присутствие соли стимулирует их рост, в то время как желчь и высокий уровень pH подавляют рост других организмов.
Как эта предположительная идентификация может помочь клиницисту: инфекции Vibrio требуют агрессивного лечения, которое включает в себя хирургическую обработку ран. При подозрении на этот микроорганизм следует немедленно начать прием соответствующих антибиотиков. Согласно литературным данным, чувствительность V. vulnificus к некоторым препаратам предсказуема, поэтому в данном случае идентификация может быть не менее полезной, чем результаты определения чувствительности.
Другие организмы, обитающие в соленой воде: V. parahaemolyticus, S. aureus.
Пациенты, которых укусили
Патогены, вызывающие инфекции укушенных ран, настолько сильно коррелируют с историей их воздействия, что микробиолог, выслушав историю болезни, будет точно знать, что искать!
Укусы собак или кошек: вспомните о Pasteurella multocida. Этот микроорганизм является основной причиной раневых инфекций после укусов, облизывания или царапин животных, особенно собак и кошек. К сожалению, этот микроорганизм может быть не принят во внимание как патоген, несмотря на его способность вызывать серьезные инфекции мягких тканей. Pasteurella является частью нормальной флоры некоторых животных, включая собак и кошек.
Другие организмы, связанные с укусами собак/кошек:

Человеческие укусы: услышав о случае укуса человека (часто в случае детей/разозленных братьев и сестер) или контакта рук с зубами человека (как в случае драк в баре у взрослых), микробиолог должен немедленно подумать о Eikenella corrodens. Для микробиолога важно заподозрить этот организм, поскольку он медленно растет и может быть пропущен в культуре. Eikenella является членом группы организмов HACEK, а Pasteurella входит в порядок Pasteurellaceae. Оба этих организма можно обнаружить в качестве нормальной флоры полости рта у людей и животных соответственно.
Окраска по Граму: оба организма представляют собой очень маленькие, короткие, грамотрицательные палочки. Их чаще называют грамотрицательными коккобациллами.
Рост на твердых средах: Eikenella очень отчетливо проявляет себя на твердых средах, особенно на шоколадном агаре. Колонии имеют отчетливый запах отбеливателя, и каждая колония обычно имеет сухой "расходящийся" ореол вокруг нее.

Колонии Eikenella corrodens на шоколадном агаре. Колонии Eikenella обычно демонстрируют распространяющийся "ореол", как показано на фото и пахнут отбеливателем.
Простой тест: и Eikenella corrodens, и Pasteurella multocida являются оксидазоположительными.

Колонии Pasteurella multocida на кровяном агаре. Колонии обычно маленькие, серые и влажные на вид.
Как эта предварительная идентификация помогает врачу: окраска по Граму, выявляющая грамотрицательные палочки, может означать очень многое. Этот организм может быть энтеральной грамотрицательной палочкой, Pseudomonas или членом группы HACEK, поэтому рассмотренные выше признаки важны для предварительной идентификации. Каждая из этих групп грамотрицательных бактерий имеет совершенно разные схемы эмпирического лечения, поэтому знание того, какая группа предполагается, может быть очень полезным. Тестирование HACEK на чувствительность к препаратам не проводится на регулярной основе из-за их плохих ростовых характеристик. Сообщение врачу о подозрении на HACEK-организм, такой как Eikenella, позволяет ему найти соответствующую литературу для руководства лечением. Кроме того, о резистентности Pasteurella сообщалось редко, и она чувствительна к большинству широко используемых антибиотиков. Знание предположительной идентификации этих организмов обеспечивает быстрое и эффективное лечение и предотвращает использование ненужных антибиотиков.
Стрептококки головы, шеи и мозга
Группа Streptococcus anginosus включает S. anginosus, S. intermedius и S. constellatus. Хотя представители группы S.anginosus не обязательно связаны с конкретной историей инфицирования пациента, они отличаются тем, что вызывают абсцессы. Они проявляют специфические характеристики в лаборатории, которые должны заставить микробиолога сильно заподозрить их роль в инфекции. Наличие абсцесса в области головы, шеи или мозга может свидетельствовать о заражении S. anginosus. Хотя этот микроорганизм в норме обитает в ротоглотке и желудочно-кишечном тракте, он склонен вызывать инфекции в этих областях, особенно в головном мозге. Это особенно актуально для педиатрических пациентов.
Окрашивание по Граму: окраска по Граму для S. anginosus не похожа на другие стрептококки. В то время как стрептококки обычно представляют собой аккуратные цепочки грамположительных кокков, S. anginosus плеоморфен, изменчив по Граму и имеет "нездоровый" вид. Отдельные клетки часто выглядят меньше, чем у типичного стрептококка, и могут казаться "разжеванными". В итоге, окраска по Граму выглядит неаккуратной, и это может быть первой подсказкой микробиолога, что S. anginosus является причиной инфекции.

Окрашивание по Граму S. anginosus. Обратите внимание на очень маленькие грамположительные кокки, слабо окрашенные и плеоморфные. Фото: A. Prinzi.
Рост на плотных средах: S. anginosus - прихотливый организм, который медленно растет на плотных средах, его характеристики роста уникальны и легко идентифицируются. Самым уникальным аспектом этого организма является сильный запах ириса, который он создает. На самом деле, этот запах настолько сильный и легко узнаваемый, что микробиолог может почувствовать его еще до того, как увидит какой-либо рост на чашках. Когда организм вырастает на плотной среде, он обычно демонстрирует маленькие, сухие колонии, похожие на перхоть.
Колонии S. anginosus, растущие на кровяном агаре. Обратите внимание на слабый бета-гемолиз и сухие маленькие белые колонии.
Как предположительная идентификация помогает клиницисту: поскольку микроорганизмы группы S. anginosus привередливы, провести тест на чувствительность к ним сложно. Полезно предупредить клиницистов о том, что анализ на чувствительность для этого организма может быть невозможен, чтобы они могли найти в литературе подходящие варианты лечения. Если клиническая служба не знала о наличии абсцесса, идентификация этого микроорганизма, например, из культуры крови, может дать им информацию, необходимую для проведения дополнительных анализов и поиска источника инфекции.
Независимо от того, какие технологии со временем внедряет микробиологическая лаборатория, история болезни пациента всегда будет одним из самых важных инструментов, которыми мы располагаем. Знание того, как предположительно идентифицировать организмы с помощью этого документа, очень важно, и это эффективный способ помочь клинической команде правильно вести пациента.
